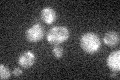
YCR107W

View description
Putative aryl-alcohol dehydrogenase with similarity to P. chrysosporium aryl-alcohol dehydrogenase; mutational analysis has not yet revealed a physiological role
Localization:
Intensity:
Fold change:
Significance:
-
C’ GFP library in SD

below threshold15.75 -
N' NOP1pr-GFP in SD

cytosol47.6504 -
N' TEF2pr-mCherry in SD

missing0 -
N' NATIVEpr-GFP in SD

below threshold18.2137 -
N' TEF2pr-VC and Cyto-VN in SD

below threshold24.1275 -
C’ GFP library in SD+DTT

cytosol17.671.12No -
C’ GFP library in SD+H2O2
cytosol17.391.1No -
C’ GFP library in Starvation Media

cytosol24.451.55No -
C’ GFP library on the background of Pup2-DaMP

below threshold -
C’ GFP library on the background of CCT mutant

below threshold17.05181.08191No
